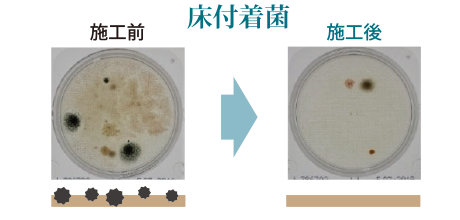

使用している檜は、 樹齢300年を超える希少価値の高い天然木曽檜です。
伊勢神宮で1300年続く「式年遷宮」という外宮内宮の建て替えの際に使われています。 除菌・消臭 cDXにはこの木曽檜の精油を配合しております。 木曽檜のみに含まれる抗菌成分のはたらきで、高い抗菌・消臭効果を発揮します。 この天然木曽檜成分はヨシキソール、ヒノキチオール、αテルビネオールなどの体に安全な天然成分なので、副作用の心配がありません。
さらに、木曽檜精油の香り成分の働きがもたらすフィトンチッド効果でホルムアルデヒドが低下し空気の浄化防虫効果があります。


PHMB(ポリヘキサメチレンビグアナイド)は世界30か国以上で殺菌剤として使用されていますが、 日本では食品加工工場や酒造工場、そして医療現場などで、その除菌、抗菌のパワーに高い評価を受けています。
コンタクトレンズの洗浄液、ウェットティッシュにPHMBが含まれており、人体にも影響の少ない安全性の高い薬剤として使われています。
テーマーパーク施設等でも水しぶきが利用者にかかるアトラクション等にもPHMBが使用されており、利用者への菌による感染を防ぐために活躍しています。
食品加工工場では、薬剤臭や腐食性を気にすることなく使用できるPHMBが機械洗浄に使用されています。


※各通販サイトに掲載中
除菌・消臭剤で使用されているアルコール、次亜塩素酸ナトリウムとPHMBの特性の比較表です。
※除菌・消臭 cDXには、アルコール、次亜塩素酸ナトリウムは含まれておりません。

抗菌力試験結果
抗菌力試験を行い、実験開始24時間後には、各種細胞は検出できない数まで 減少し、高い抗菌効果が確認されました。

公衆施設や公衆トイレなどニオイやカビがつきやすい場所

ホテルの客室での除菌・抗菌や消臭

強いニオイが残りやすい喫煙所のタバコ臭

入居前のニオイ・カビ予防リフォーム時のお部屋や特殊清掃に

ジムやフィットネスなどの施設内の除菌・消臭

授乳室、ベビー休憩室などの衛生面を重視したスペース

犬や猫などのペット臭

オフィスや会議室など様々な社内の除菌・消臭

医療施設の除菌・消臭

介護施設の除菌・消臭

タクシーなどの座席シート

学校教室の除菌・消臭

リビングや家具の布製品

キッチン

バスルーム

ベッドルーム
不動産管理会社
宿泊施設運営会社
リゾート施設運営会社
介護施設運営会社
医療機関運営会社
フィットネスクラブ運営会社
タクシー事業運営会社
建設設計事務所



※各通販サイトに掲載中
